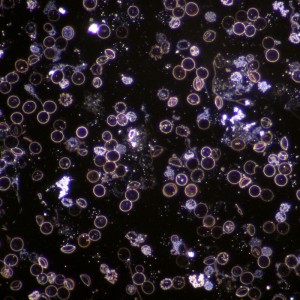
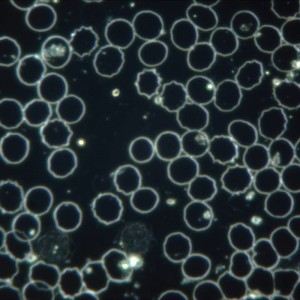
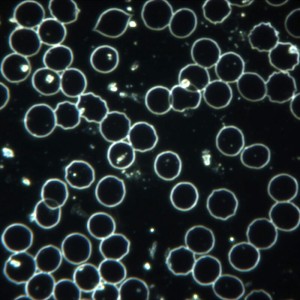
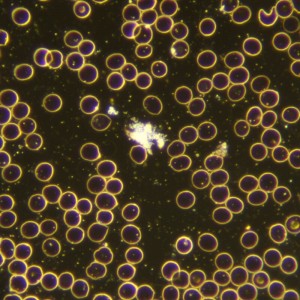

Microscop LACERTA LIS-CDF
În curând
9 880.00 Lei
Cod produs: LIS-CDF
Descriere
Microscop LACERTA LIS-CDF
Recomandat pentru analiza sangelui proaspat.
Caracteristici
- Doua oculare: 10x WF20
- Cap trinocular: cap binocular si adaptor pentru camera (cu suficient back-focus pentru montarea unui aparat foto DSLR)
- Adaptor oculare (cap binocular) tip Seidentopf inclinatla 30 de grade.
- Distanta interpuilara reglabila intre 55 si 75mm.
- Se poate roti 360 grade.
- Turela pentru obiective cu cinci pozitii.
- Cinci obiective INFINITY Plan: 4x, 10x, 40x, 100x
- Iluminator Koehler, intensitate reglabila
- Focus fin si grosier
- Condensator cu diafragma iris N.A.= 1.25
- Suport tip potcoava pentru accesorii de iluminare: campluminos, camp intunecat, polarizare, contrast de faza.
- Garantie: 2 ani

 Oferte speciale
Oferte speciale  Idei de cadou
Idei de cadou  Monturi si accesorii
Monturi si accesorii  Accesorii telescop
Accesorii telescop  Astrofotografie
Astrofotografie  Carți si atlase
Carți si atlase Microscoape
Microscoape  Accesorii microscoape
Accesorii microscoape  Lupe manuale
Lupe manuale Binocluri
Binocluri  Lunete terestre
Lunete terestre Trepiede foto
Trepiede foto

![Microscop stereo Delta IPOS-808 PLAN (8-64x) [7-30] Microscop stereo Delta IPOS-808 PLAN (8-64x) [7-30]](https://soldigo.azureedge.net/images/7265/300x300/gspfgwykfg.jpg)
![Microscop stereo Delta IPOS-810 PLAN (8-80x) [7-30] Microscop stereo Delta IPOS-810 PLAN (8-80x) [7-30]](https://soldigo.azureedge.net/images/7265/300x300/fwjwevldb6.jpg)
![Microscop LACERTA LISpol-1 [5-7] Microscop LACERTA LISpol-1 [5-7]](https://soldigo.azureedge.net/images/7265/300x300/wikxz4mnqj.jpg)
![Microscop LACERTA LISpol-4 [7-17] Microscop LACERTA LISpol-4 [7-17]](https://soldigo.azureedge.net/images/7265/300x300/m3to9nmwtq.jpg)









